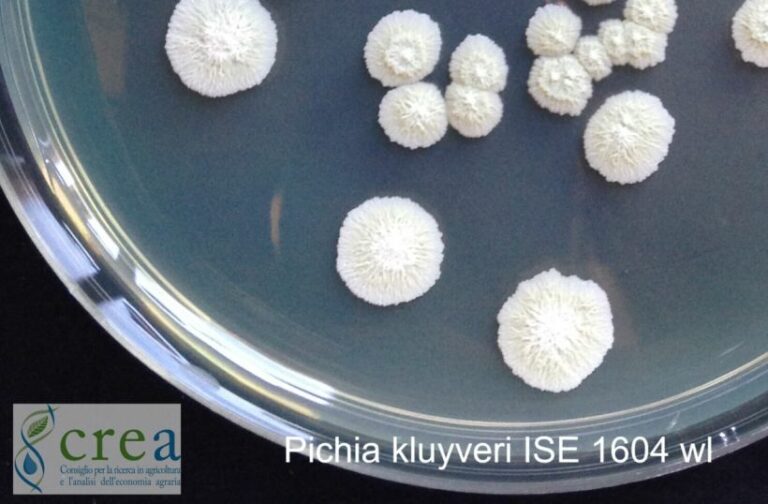
Crea, collezione microbica del vino nell’organizzazione Ue

ROMA (ITALPRESS) – La collezione microbica del CREA Viticoltura ed Enologia CREA-CMVE (CREA-Collezione di Microorganismi di habitat Viticolo Enologico) è stata ammessa in ECCO (European Culture Collections’ Organisation), una delle più importanti organizzazioni internazionali che si occupano di biodiversità microbica. I microrganismi svolgono un ruolo fondamentale ma ancora sottovalutato per la definizione di “terroir” ed in generale per la qualità del vino. Ad oggi, la collezione conta circa 1400 isolati (ceppi conservati come coltura pura) di lieviti e 280 isolati di batteri lattici, conservati in tripla copia a -80°C. Recentemente, è stata inserita una piccola collezione di batteriofagi, virus che attaccano i batteri lattici. La collezione è stata corredata con il DNA purificato estratto da tutti i ceppi e completamente riesaminata con metodi molecolari basati su analisi genetiche, arrivando alla discriminazione oggettiva delle singole specie e, addirittura, alla distinzione di un singolo ceppo all’interno della specie con metodi molto simili a quelli utilizzati dalla polizia scientifica. Dal 2017 la collezione è censita dal Culture Collection Information Worldwide (CCINFO) del World Data Centre for Microorganisms (WDCM). Gli isolamenti più recenti sono frutto delle attività di ricerca scientifica, dalla sperimentazione relativa alla selezione di lieviti e batteri ecotipici, alla valutazione della biodiversità in vigneto, alle analisi conto terzi rivolte all’identificazione di contaminanti del vino ritrovati nelle bottiglie o nelle attrezzature di cantina. La collezione di microrganismi enologici ricopre un ruolo importante come fonte di “biodiversità metabolica” che si riflette sulle qualità di un vino prodotto. Grazie a determinate capacità enzimatiche presenti nei ceppi della collezione si possono ottenere, ad esempio, profumi migliorati o accentuati, maggiore struttura o colore più stabile nei rossi e si potrebbero risolvere diversi problemi tecnologici legati alle produzioni enologiche. La biodiversità microbica presente in natura, di cui la collezione CREA non è che un’infinitesima frazione, permette di andare oltre la standardizzazione derivante dall’uso di uno o pochi microrganismi per ogni tipo di produzione enologica, abbracciando l’idea di un’enologia di precisione di tipo “sartoriale” dove ogni vino, ogni singola denominazione, ha un suo microrganismo, selezionato “su misura”.
(ITALPRESS).
-foto ufficio stampa Crea-
Crea, collezione microbica del vino nell’organizzazione Ue
Da Barilla a Voiello, Mondadori pubblica poster grandi aziende italiane
SEGRATE (MILANO) (ITALPRESS) – Dalla collaborazione con gli archivi storici delle più grandi aziende italiane nasce “Poster, le grandi aziende italiane”, la speciale iniziativa editoriale firmata dal Gruppo Mondadori dedicata a tutti gli appassionati di tesori senza tempo di arte pubblicitaria. L’iniziativa coinvolge alcuni dei principali brand storici italiani noti al grande pubblico – Barilla, Manetti & Roberts, Martini, Pavesi, Pirelli, Olivetti, Ducati, Fabbri 1905, Voiello – e riporta alla luce dieci manifesti d’epoca unici di grande valore artistico e culturale che hanno lasciato un’impronta nel panorama pubblicitario dagli anni Trenta agli anni Novanta. A partire da questa settimana, in selezionati punti vendita, tutti gli amanti di collezionismo vintage potranno accedere alle prime cinque opere in edizione limitata: “Notte di Stelline”, il poster tratto dallo storico Calendario murale di Adolfo Busi, realizzato nel 1931 per Barilla, l’azienda fondata da Pietro Barilla 145 anni fa. La tavola ha come protagonisti dei bambini paffuti e dinamici che giocano con formati di pasta, dimostrando così che si tratta di un prodotto che fa bene e dà energia: una risposta indiretta al Manifesto della cucina Futurista che esortava all’abolizione della pastasciutta.
“Venere moderna”, l’iconico manifesto pubblicitario di Manetti & Roberts. Disegnato negli anni Trenta dall’artista pugliese Gino Boccasile, si ispira all’eleganza e maternità della figura femminile dell’epoca e ritrae un bambino che cosparge giocosamente la “Venere moderna” di Borotalco. “Jockey”, l’opera commissionata da Martini al pittore francese Jean Droit nel 1948. Con grande attenzione ai dettagli e una spiccata potenza espressiva, il soggetto di Jockey rivisita metaforicamente una competizione ippica, con i fantini a cavallo di bottiglie di vermouth: uno primeggia su Martini, altri due inseguono sullo sfondo. “Bambino con i Pavesini”, disegnato da Gian Carlo Rossetti nel 1961, ripropone l’immagine senza tempo del bambino dei Pavesini, una rappresentazione che verrà ripetutamente aggiornata e riproposta negli anni anche per indicare che i Pavesini sono un prodotto adatto anche ai più piccoli dal punto di vista nutrizionale.
“Pneumatico Cinturato Pirelli”, un manifesto del 1961 dell’azienda Pirelli realizzato da Riccardo Manzi. L’artista, che firma copertine e pubblicità con stile umoristico, porta colore e allegria nelle grafiche rendendo popolare un prodotto necessario: pneumatici rinforzati che garantiscono la totale sicurezza alla guida del mezzo anche qualora, paradossalmente e ironicamente, il conducente avesse la vista impedita. La seconda collezione in edizione limitata sarà disponibile in selezionati punti vendita dal 17 novembre: “Vera pasta all’uovo”, l’illustrazione dell’emblematica gallina cubista che ricorda la qualità della pasta Barilla, è stata realizzata nel 1954 da Erberto Carboni, il grande grafico e coordinatore dell’immagine aziendale. Si tratta di un vero e proprio omaggio alla qualità della materia prima. “Tetractys”, la locandina pubblicitaria creata nel 1956 da Giovanni Pintori, il designer che, grazie alle sue originali opere, ha permesso ai prodotti Olivetti di essere conosciuti e riconosciuti in tutto il mondo. L’illustrazione arborescente di Tetractys sottolinea le potenzialità “proliferative” della calcolatrice Olivetti.
La Ducati 916, autentica opera d’arte in movimento creata nel 1993 dal designer Massimo Tamburini, incarna i valori fondanti di Ducati: Style, Sophistication e Performance. Probabilmente il più iconico tra i modelli dell’azienda motociclistica, la moto incontra tecnologia e design in una sintesi mai vista prima: i suoi gruppi ottici rastremati, al centro del poster, hanno ipnotizzato il mondo negli anni Novanta. “Brezza che ristora”, il poster pubblicitario dell’Amarena Fabbri (Fabbri 1905) che risale agli anni Quaranta: un invito ad affrontare il caldo estivo con l’azienda da sempre famosa per i suoi storici legami con il mondo della pubblicità – con Carosello e con Fabbri racconta “un pittore alla settimana – Renato Gottuso” – e quello dell’arte con il Premio Fabbri per l’Arte. Lo stampato Voiello – main sponsor di “Procida Capitale Italiana della Cultura 2022” – è stato realizzato negli anni ’10 del Novecento. Non si conosce l’autore ma è evidente la rappresentazione allegorica della mediterraneità, di Napoli – a sottolineare il legame con il territorio – i messaggi sull’italianità, la qualità degli ingredienti e del processo produttivo.
I poster – disponibili nelle edicole in espositori progettati ad hoc che ne rafforzano l’unicità – sono in vendita corredati da esclusivi booklet, opuscoli informativi dove gli amanti del collezionismo potranno scoprire la storia del prodotto, curiosità sugli artisti, approfondimenti sulle aziende e tanto altro. Le dieci opere pubblicitarie sono disponibili nelle migliori edicole e presso le principali insegne della grande distribuzione al prezzo di 8,90 euro cadauna.
foto: ufficio stampa Mondadori
(ITALPRESS).
Campagna #NoFakeFood a tutela del made in Italy
ROMA (ITALPRESS) – Secondo le ultime stime della Coldiretti, è salito da 100 a 120 miliardi il valore del falso Made in Italy agroalimentare nel mondo. Per rilanciare l’impegno a difendere agricoltura e agroalimentare italiani, Fondazione UniVerde, Federazione Italiana Cuochi – FIC, in collaborazione con Coldiretti Lazio, hanno promosso l’evento “Agricoltura e Made in Italy. Agroaperitivo e campagna #NoFakeFood con prodotti agroalimentari tradizionali”, presso La Serra del Palazzo Esposizioni. Per Alfonso Pecoraro Scanio, presidente della Fondazione UniVerde e promotore campagna #NoFakeFood, “agropirateria e italian sounding sono fenomeni diffusi che sottraggono miliardi di euro al nostro export, con quantitativi di cibi contraffatti che superano in valore quello degli originali. Si tratta non solo di tutelare la qualità e l’immagine del nostro Paese, ma anche la genuinità del prodotto italiano nel mondo dall’immissione sul mercato di cibi che di italiano non hanno nulla. E’ una concorrenza sleale nei confronti di imprenditori seri – ha spiegato – che sottrae importanti quote di mercato al vero Made in Italy, risorse e opportunità di lavoro all’Italia, in un momento di particolare difficoltà per le nostre aziende. Ecco perchè occorre investire sulla diffusione di tutte le tecnologie che garantiscono tracciabilità e sicurezza”.
Alessandro Circiello, portavoce della Federazione Italiana Cuochi ha sottolineato come “sarebbe utile creare un ministero per la tutela e il sostegno al Made in Italy che difenda e valorizzi tutto ciò che è fatto in Italia, che accorpi in un unico dicastero tutte quelle deleghe attualmente sparse in più realtà istituzionali che troppo spesso non sono in sinergia tra di loro”. Per il ministro uscente delle Politiche agricole, Stefano Patuanelli, “l’Italia vanta il maggior numero di prodotti a marchio registrato e al tempo stesso è uno dei Paesi più colpiti da tentativi di contraffazione e italian soundig che danneggiano i mercati, i produttori e i consumatori. Per tutelare il patrimonio agroalimentare è essenziale comunicare informazioni complete ed esaustive sulla tracciabilità e l’origine dei prodotti, veicolare il valore di stili di vita e consumo salubri e continuare a perseguire tutti quei comportamenti fraudolenti che minano le corrette relazioni di mercato ma anche supportare e favorire la transizione digitale del sistema produttivo”. Jimmy Ghione, testimonial della campagna #NoFakeFood, ha evidenziato come co la campagna “vogliamo tutelare i produttori italiani vittime della contraffazione e dei prodotti taroccati”.
Per David Granieri, presidente Coldiretti Lazio, “dobbiamo proteggere le produzioni agricole tipiche del Made in Italy e le nostre eccellenze Made in Lazio. E’ importante difendere quegli spazi di autonomia e sovranità alimentare che fino a oggi le imprese agricole italiane sono riuscite a tutelare per il bene del Paese”.
(ITALPRESS).
-foto ufficio Stama Fondazione Univerde-
Consorzio Parmigiano Reggiano al Sial di Parigi
REGGIO EMILIA (ITALPRESS) – Il Consorzio del Parmigiano Reggiano sarà protagonista al Sial, l’evento biennale b2b dedicato al food che si terrà a Parigi da domani a mercoledì 19 ottobre. Un’edizione che vede il patrocinio dello chef Mauro Colagreco, accomunato all’organizzazione del Sial dall’impegno per il cambiamento ambientale, etico, digitale e demografico del Pianeta. Per quest’anno sono attesi 7.020 espositori provenienti da 119 paesi, con oltre 400.000 prodotti alimentari esibiti.
L’appuntamento è tanto più importante se si considera che la Francia rappresenta per la Dop il primo export market UE e il secondo al mondo dopo gli Usa: nei primi nove mesi del 2022 sono infatti state 9.323 le tonnellate destinate al mercato d’Oltralpe, in aumento del +7,2% rispetto allo stesso periodo del 2021. Il tutto in una cornice economica che vede, nello stesso lasso di tempo, le vendite totali del Parmigiano Reggiano nel mondo crescere del +2,9%. “Siamo molto orgogliosi di poter rinnovare anche quest’anno la nostra partecipazione a questa importante manifestazione”, ha dichiarato Nicola Bertinelli, presidente del Consorzio Parmigiano Reggiano. “Un evento dalla risonanza non solo nazionale, in quello che è il nostro primo mercato di riferimento nell’area UE, ma mondiale. Una dimensione internazionale in cui il Parmigiano Reggiano è sempre più proiettato, con una quota export di oltre il 45%. Parmigiano Reggiano si avvia sempre più a diventare un vero brand globale e il Consorzio sta lavorando assiduamente verso questo obiettivo”, ha aggiunto.
(ITALPRESS).
-foto ufficio stampa Consorzio Parmigiano Reggiano-
Al via progetto coordinato da Enea per la sicurezza alimentare
ROMA (ITALPRESS) – Rafforzare l’eccellenza scientifica italiana nella sicurezza alimentare attraverso lo sviluppo di piattaforme e servizi per la qualità, autenticità e rintracciabilità di materie prime e prodotti e per la digitalizzazione del settore.
E’ l’obiettivo del progetto Metrofood-It finanziato con 17,8 milioni dal Pnrr e coordinato da Enea. Il progetto al quale partecipano l’Istituto Nazionale di Ricerca Metrologica (Inrim) e le Università di Bari, Federico II di Napoli, Molise, Parma, Sapienza di Roma e Siena, è stato lanciato a pochi giorni dalla Giornata mondiale dell’alimentazione che ricorre ogni anno il 16 ottobre. Enea metterà a disposizione 11 tra infrastrutture e laboratori dislocati in 5 centri ricerche, 6 unità operative oltre a un mix di tecnologie Ict, quali app, software e modelli per fornire servizi e sviluppare una piattaforma open data utile a ricercatori, agenzie di ispezione e controllo, policy maker, aziende e cittadini per incrementare qualità, sicurezza, tracciabilità ma anche food transparency ed economia circolare.
Nello specifico, per conseguire questi obiettivi Enea metterà in campo: i laboratori di metabolomica, spettroscopia atomica, spettrometria di massa e caratterizzazione di nanoparticelle, microbiologia e l’impianto di irraggiamento gamma Calliope presso il Centro Ricerche Casaccia (Roma); il laboratorio Smart sensors & IoT del Centro Ricerche di Frascati (Roma); l’impianto Materiali di Riferimento agroalimentari e la Facility NMR nel Centro Ricerche Trisaia (Matera); la Facility di bioeconomia circolare nel Centro Ricerche di Brindisi; il supercomputer CRESCO6 del Centro Ricerche di Portici (Napoli).
“Abbiamo voluto presentare il progetto a pochi giorni dalla Giornata mondiale dell’alimentazione che ricorre ogni anno il 16 ottobre perchè il suo contributo sarà fondamentale per raggiungere gli obiettivi prioritari del settore agroalimentare”, evidenzia Claudia Zoani, della divisione Biotecnologie e Agroindustria e coordinatrice del progetto. “Tra i più importanti la trasparenza, soprattutto tra microimprese e pmi, la riduzione delle frodi e delle sofisticazioni, la food defense e i sistemi di controllo dei processi di produzione, la digitalizzazione, il supporto ai policy makers e alle agenzie di ispezione e controllo, la fiducia dei consumatori e la sensibilizzazione verso l’adozione di diete più sane e sostenibili, la riduzione degli sprechi di cibo”, conclude.
(ITALPRESS).
-foto ufficio stampa Enea-
L’eccellenza italiana torna al Sial di Parigi
ROMA (ITALPRESS) – Dopo due anni di stop, il Sial di Parigi torna con un’edizione all’insegna della sostenibilità alimentare. Un’attenzione particolare al tema di grande attualità e in risposta alle aspettative dell’intero ecosistema alimentare: produrre di più ma inquinando meno, esplorare nuove fonti e risorse di approvvigionamento, puntando su una maggiore trasparenza. Sial Paris si conferma appuntamento imperdibile per l’intera industria alimentare internazionale, come dimostrano i numeri tornati ai livelli del 2018: 7.200 espositori provenienti da 120 Paesi, con una percentuale estero del 90%, l’Italia come seconda rappresentanza circa 800 aziende presenti e 310.000 operatori attesi nei 5 giorni della manifestazione.
Quest’anno a Parigi Universal Marketing coordinerà la partecipazione di diverse aziende. In linea con il tema principale di questa edizione, le aree italiane saranno strutturate per esaltare al meglio tutta la qualità e la creatività che il “Bel Paese” è in grado offrire.
“Il cibo italiano come sappiamo è tra i più amati dai consumatori di tutto il mondo – ha dichiarato Nicolas Trentesaux direttore generale di Sial Network – Il merito della forza del cibo italiano all’estero va attribuito in larga parte al dinamismo delle aziende alimentari italiane desiderose di andare all’estero e condividere la loro passione per il cibo. E’ importante segnalare – ha continuato Trentesaux – anche la considerevole opera da parte di enti nazionali e regionali a sostegno della promozione territoriale nei mercati internazionali, sia attraverso una forte rappresentanza agli eventi fieristici, ma anche attraverso l’attività di PR che nel lungo periodo hanno permesso una rilevante azione sia di percezione che di penetrazione nei mercati di riferimento. Un grazie speciale – ha concluso Trentesaux – alla Universal Marketing, che nei tanti anni di collaborazione con il Sial, ha facilitato, l’ingresso ed il giusto approccio per distretti ed aziende italiane in un contesto altamente competitivo e pieno di tante opportunità. Non vediamo l’ora di stare tutti insieme presto a Parigi”.
“Finalmente si torna a Parigi – ha dichiarato Donato Cinelli, presidente di Universal Marketing, agente esclusivo per l’Italia del Sial – e torniamo subito da grandi protagonisti a dimostrazione di quanto sia, oggi piùche mai, importante e strategico il ruolo dell’Italia nella fiera agroalimentare più importante in Europa. Ancora una volta le aziende italiane hanno scelto con forza il Sial di Parigi, e di questo siamo molto contenti, perchè da oltre 25 anni come Universal Marketing abbiamo puntato tantissime risorse su questo appuntamento, da sempre convinti delle grandi potenzialità del progetto espositivo. Da sempre la nostra missione, – ha concluso Cinelli – è portare le aziende italiane nei grandi centri di attenzione internazionale, e il Sial Parigi è la sua massima espressione”.
(ITALPRESS).
-foto Gp Comunication-
Per gli italiani l’agricoltura uno dei settori chiave per lo sviluppo
ROMA (ITALPRESS) – Per il 90% degli italiani (+7%) è necessaria una certificazione che garantisca l’origine dei prodotti agroalimentari made in Italy all’estero: lo conferma il XII Rapporto “Gli italiani e l’agricoltura” presentato in diretta streaming con il ministro Stefano Patuanelli (Mipaaf) e Jimmy Ghione (Inviato di Striscia la Notizia e testimonial della campagna #NoFakeFood). I dati dell’indagine, realizzata da Fondazione UniVerde e Noto Sondaggi, in collaborazione con ITA0039 – 100% Italian Taste Certification by Asacert, confermano l’agricoltura italiana come un settore strategico del sistema Paese che punta alla qualità dei prodotti, alla multifunzionalità e alla difesa del territorio.
Alfonso Pecoraro Scanio, Presidente della Fondazione UniVerde e promotore della campagna #NoFakeFood contro agropirateria e in difesa dell’Italian taste, ha dichiarato che “dal Rapporto è evidente che gli italiani ritengono l’agricoltura uno dei settori chiave per lo sviluppo dell’economia del Paese. Proprio dalla riforma che ho firmato nel maggio 2001, sono nate quelle realtà che oggi rappresentano le nuove forze di rilancio, in termini di eccellenza delle produzioni, di tutela del territorio e della proposta di servizi. Tuttavia, i dati del XII Rapporto evidenziano la tendenza secondo cui per i prodotti agroalimentari made in Italy all’estero è necessaria una certificazione che ne garantisca l’origine (confermato dal 90% degli italiani, +7% rispetto alla scorsa rilevazione). Su questo tema – ha aggiunto – occorre dunque costruire una competenza anche nel prossimo Governo, rilanciando l’importanza della tutela del comparto agroalimentare italiano dalle contraffazioni. Ciò permetterebbe di recuperare miliardi di euro di possibile export e di aumentare l’occupazione in questo settore in un momento particolare di difficoltà”.
“La tutela dell’agroalimentare – ha sottolineato il ministro Patuanelli – è stato uno dei temi su cui mi sono maggiormente battuto in questi diciotto mesi in cui ho avuto il privilegio di guidare il Mipaaf. Le azioni di promozione rappresentano uno degli strumenti più efficaci per lo sviluppo del settore, ancor più se vedono il coinvolgimento della filiera, delle rappresentanze di settore e delle componenti politiche sia nazionali che territoriali. Accompagnare anche le piccole produzioni agroalimentari, che rappresentano un grande valore simbolico per il nostro Paese è una delle missioni di questo Ministero. Il consumatore, come ha confermato anche lo studio che è stato presentato oggi, vede nella certificazione un valore aggiunto nel momento dell’acquisto o del consumo del prodotto. Proprio per questo è necessario continuare a lavorare sia nel mercato interno che in quello estero per porre al centro dell’azione politica la difesa dei prodotti certificati, attraverso forme di etichettatura che non creino condizionamento ma informazione, la tutela della dieta mediterranea e opporsi a ogni tentativo di omologazione alimentare, imitazioni, contraffazioni e fake news che non fanno che danneggiare alcune delle più importanti filiere nazionali e tradire la fiducia del consumatore”.
Per Fabrizio Capaccioli, Managing Director Asacert e ideatore del Protocollo ITA0039, “questi dati ci forniscono un importante sguardo d’insieme sul modo in cui gli italiani percepiscono lo stato della tutela dei prodotti agroalimentari Made in Italy. Secondo il campione preso in considerazione, i prodotti italiani non sono sufficientemente tutelati per il 69% degli intervistati, con un peggioramento percepito rispetto al 2020 di ben 8 punti. Dato coerente con il 90% (dato maggiore di ben 12 punti rispetto al 2020) fatto registrare da coloro che ritengono necessaria una certificazione che garantisca l’effettiva provenienza 100% italiana dei prodotti della nostra tradizione agroalimentare presenti anche nei ristoranti all’estero. Un’indagine significativa che conferma la necessità di agire. ITA0039 | 100% Italian Taste Certification by Asacert si impegna da anni per la tutela e la valorizzazione del mercato enogastronomico italiano, grazie al protocollo di certificazione e all’app. I tecnici Asacert verificano l’effettiva ‘italianità’ nel mondo della ristorazione attraverso scrupolose e metodiche attività di audit”.
“Tutela e affidabilità certificata da un ente terzo, a garanzia di produttori, ristoratori e consumatori di tutto il mondo. Il nascente Osservatorio sul Fakefood, sarà uno strumento concreto per diffondere e valorizzare cultura, identità a salvaguardia dell’economia e della salute dei consumatori”, ha aggiunto.
“Sono felice di sostenere l’iniziativa promossa da Alfonso Pecoraro Scanio per difendere e valorizzare la qualità delle produzioni e del cibo italiani – ha detto Jimmy Ghione -. Con Striscia siamo impegnati da anni nella lotta alla contraffazione e all’Italian sounding testimoniando questi fenomeni che aggrediscono il made in Italy, anche con servizi in giro per il mondo. Occorre intervenire con decisione per difendere le imprese oneste che producono sui territori di origine alimenti genuini”.
Antonio Noto, Direttore di Noto Sondaggi, ha presentato i dati del XII Rapporto secondo cui l’86% degli italiani conosce e considera l’agricoltura multifunzionale un importante settore di sviluppo dell’economia italiana (+3% rispetto alla precedente rilevazione).
Nonostante si ritenga da incentivare l’attenzione riservata all’agricoltura (64%), il trend di chi valuta adeguato l’impegno delle Istituzioni è in costante crescita arrivando a toccare il 32% (+6% rispetto alla precedente rilevazione). Anche se si ritiene che la condizione degli agricoltori sia da valorizzare ulteriormente, il dato relativo a chi la valuta cambiata in meglio aumenta di quattro punti percentuali rispetto alla scorsa analisi (16% contro 12%). Si riduce inoltre la forbice tra coloro che percepiscono il lavoro degli agricoltori come poco remunerativo (dal 72% della precedente rilevazione al 66% dell’attuale Rapporto) e cresce di sette punti percentuali la valutazione di chi lo riconosce equo, sfiorando il 20% del campione. Il 71%, inoltre, ritiene i prodotti agricoli italiani più saporiti, più genuini (72%) e più controllati (70%, ben +10%) rispetto a quelli provenienti dagli altri Paesi.
La diretta streaming, moderata da Mariaelena Leggieri (Giornalista di TeleAmbiente) e promossa con la media partnership di Italpress, Askanews, TeleAmbiente, Opera2030, SOS Terra Onlus, segue l’anticipazione del XII Rapporto “Gli italiani e l’agricoltura”, con focus sugli agriturismi, realizzata da Fondazione UniVerde e Noto Sondaggi, in collaborazione con Coldiretti e Campagna Amica, presentata a Roma il 17 giugno scorso a Palazzo Rospigliosi, in occasione della XXXIV Assemblea Nazionale di Terranostra, alla vigilia della Giornata Internazionale per la Gastronomia Sostenibile 2022 proclamata dall’Onu.
– foto ufficio stampa Fondazione Univerde –
(ITALPRESS).
Parmigiano Reggiano, nei primi 9 mesi del 2022 vendite +2,9%
ROMA (ITALPRESS) – Nel corso dell’Assemblea generale dei consorziati, il Consorzio Parmigiano Reggiano ha presentato i dati economici del terzo trimestre (gennaio – settembre 2022). Dopo aver chiuso un 2021 positivo, con un giro d’affari al consumo pari a 2,7 miliardi di euro, nel 2022 il Consorzio registra – rispetto ai primi nove mesi del 2021 – un incremento delle vendite totali pari al 2,9% (95.079 tonnellate vs 92.366 tonnellate), con un aumento dei volumi anche nei mercati internazionali, che crescono dell’1,3% (43.887 tonnellate vs 43.331).
Segno positivo anche per le vendite nel mercato italiano: +4,4% (51.191 tonnellate vs 49.035), grazie alla ripresa del canale della ristorazione e delle vendite dirette che aumentano del 4% (10.990 tonnellate vs 10.570 tonnellate).
Le aziende del Consorzio Parmigiano Reggiano hanno quindi reagito bene alla pandemia, alle incognite legate alle incertezze della crisi geopolitica accesasi con l’invasione russa del 24 febbraio, al caro energia e alla riduzione del potere di acquisto delle famiglie in alcuni mercati.
Prima nello sviluppo, la Spagna (+12,4% con 999 tonnellate vs 889 tonnellate del terzo trimestre 2021), bene anche Stati Uniti, primo mercato estero per la Dop Parmigiano Reggiano (+8,2% con 10.326 tonnellate vs 9.539 tonnellate), e Francia (+7,2% con 9.323 tonnellate vs 8.697 tonnellate).
Buoni i risultati anche Oltreoceano, con il Giappone che cresce del 51% (632 tonnellate vs 419) e l’Australia che segna un +12,7% (381 tonnellate vs 338 tonnellate).
“Il terzo trimestre 2022 conferma il sostanziale ‘premiò dei consumatori, che dalla pandemia continuano a dimostrare fedeltà ai valori della nostra Dop, con un +2,9% di crescita a volume”, ha commentato Nicola Bertinelli, presidente del Consorzio Parmigiano Reggiano.
“Nonostante i risultati positivi, siamo preoccupati dalla situazione economica italiana e dalle difficoltà che stanno affrontando le famiglie per l’aumento dei prezzi e per il caro energia. Per questo motivo, il Consorzio ha adottato un pacchetto di azioni straordinarie per un importo pari a 850mila euro: si tratta di attività promozionali in collaborazione con le più importanti insegne della GDO mirate a sostenere la domanda in un periodo di grande incertezza che potrebbe portare a una contrazione dei consumi del nostro prodotto”, ha commentato il presidente Bertinelli.
Sempre in un’ottica di esigenza di equilibrio tra domanda e offerta da consolidare nel mercato e di tutela ulteriore del prodotto, l’Assemblea ha inoltre affrontato il tema delle norme che regolano la produzione di formaggi similari/comparabili al Parmigiano Reggiano, modificando lo statuto e introducendo il divieto di produrre, nei caseifici della filiera, altri formaggi comparabili/confondibili con la Dop.
L’Assemblea ha infine deliberato di portare la franchigia di esenzione contributiva al 3% rispetto alla contribuzione aggiuntiva prevista dal piano di regolazione dell’offerta come misura di avvicinamento al nuovo piano. In sostanza, la franchigia va a stabilire il volume dell’eccedenza produttiva non assoggettata alla “contribuzione aggiuntiva” fissata dal Consorzio a carico dei caseifici in caso di superamento degli obiettivi assegnati.
– foto ufficio stampa Consorzio Parmigiano Reggiano –
(ITALPRESS).